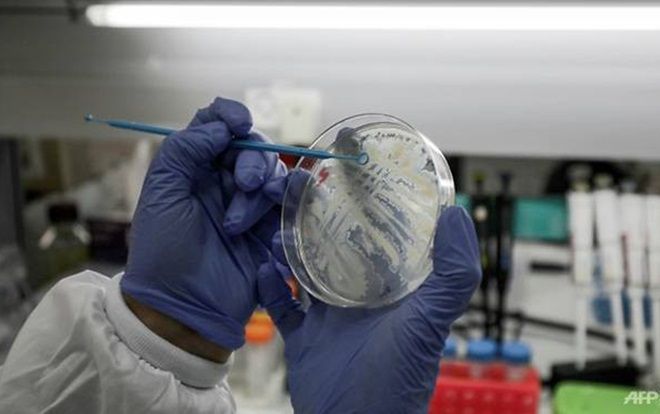
Điều gì xảy ra nếu thế giới vẫn chưa tìm ra vaccine ngừa Covid-19?

Tìm kiếm từ khoá
#vaccine
Saostar cập nhật tin tức, sự kiện, hình ảnh, video clip hot nhất 24h qua về chủ đề vaccine


Thị trưởng suýt bị lừa mua 30 triệu liều vaccine

Trong đêm ra mắt, quỹ vaccine phòng chống COVID-19 nhận thêm 17 tỷ đồng qua cổng tin nhắn

Mỹ chia sẻ 25 triệu liều vaccine COVID-19 với các nước, trong đó có Việt Nam

Người đàn ông đầu tiên trên thế giới tiêm vaccine Covid-19 đã qua đời

50% người lớn Mỹ tiêm xong vaccine, EU đạt miễn dịch cộng đồng vào tháng 7

Thêm 288.000 liều vaccine AstraZeneca về đến Việt Nam trong đêm

Nhiều nước châu Á có nguy cơ thành 'Ấn Độ thứ hai' trước làn sóng dịch Covid-19

Tỷ phú Bill Gates: 'Cuối năm 2022, thế giới trở lại trạng thái bình thường'

Việt Nam vừa phê duyệt vaccine phòng Covid-19 Sputnik V của Nga cho nhu cầu cấp bách phòng dịch

Biến thể mới của virus SARS-CoV-2 có thể 'qua mặt' kháng thể chống lại virus bản gốc

Những câu hỏi còn bỏ ngỏ về vaccine COVID-19
.jpg)
Tiêm vắc xin COVID-19 gặp biến chứng, đòi bồi thường được không?

Sợ xét nghiệm COVID-19 không thể về quê ăn Tết, người đàn ông có hành động dại dột này trên đường cao tốc

Chuyên gia cảnh báo SAR-CoV-2 'sẽ tồn tại mãi mãi'
.jpg)
Nga trở thành quốc gia đầu tiên trên thế giới 'trình làng' vaccine COVID-19
.jpg)
Nga sắp tiêm đại trà vaccine ngừa COVID-19
Điều gì xảy ra nếu thế giới vẫn chưa tìm ra vaccine ngừa Covid-19?

Mỹ có thể cần giãn cách xã hội tới 2022 nếu chưa có vaccine điều trị COVID-19
